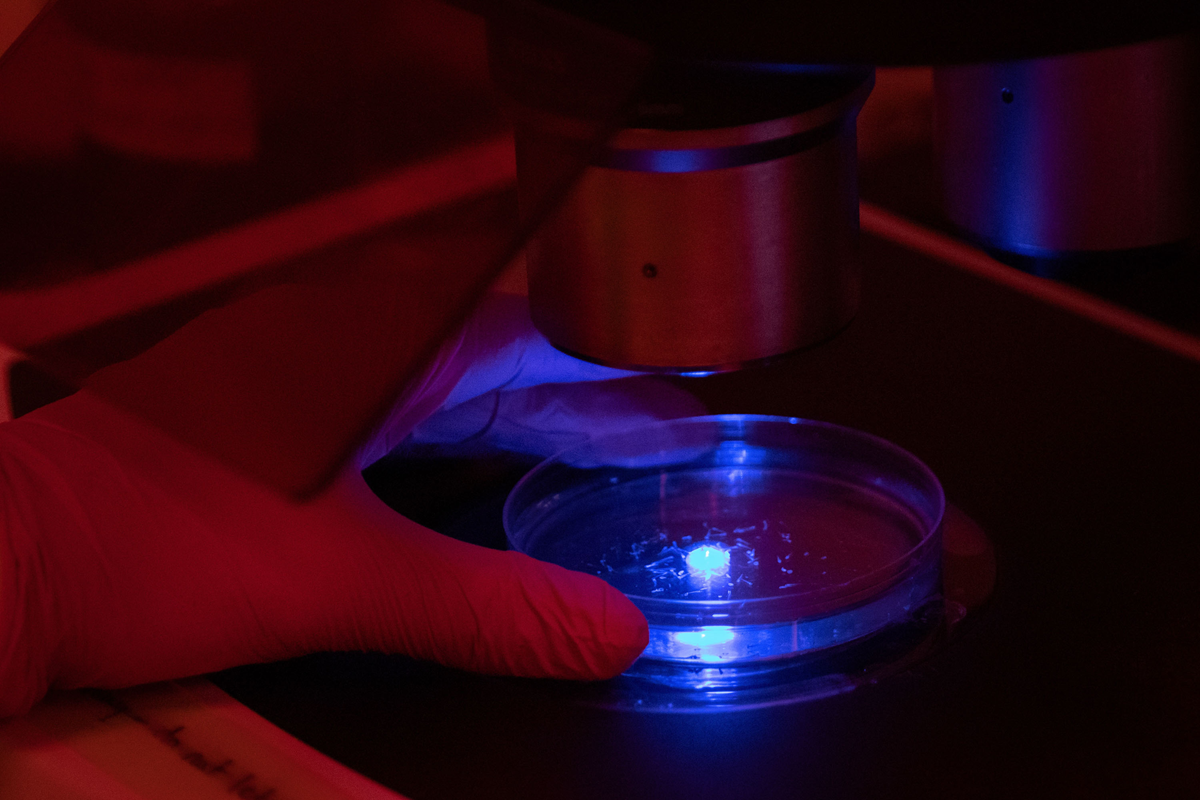
Petri dish under microscope lit with blue light

News & Stories
Read the latest news and stories in the SickKids newsroom. Looking to interview someone? Connect with our media team.

October 26, 2023
Dr. Zulfiqar Bhutta awarded prestigious Sitara-e-Imtiaz for outstanding contributions to Pakistan
Dr. Zulfiqar Bhutta at the SickKids Centre for Global Child Health (C-GCH) has been conferred the Sitara-e-Imtiaz (Star of Excellence) in recognition of his lifetime of exceptional contributions to the country of Pakistan. This is one of the highest honours and civil awards in Pakistan.

October 24, 2023
Liquid biopsy improves early cancer detection and diagnosis in patients with LFS
Research shows a blood sample analysis may detect cancer earlier in individuals with Li-Fraumeni syndrome.

October 23, 2023
The Advanced Practice Nurse Council is made up of more than 150 nurse practitioners and clinical nurse specialists across the organization.

October 16, 2023
Researchers investigate a new method of sedation for paediatric patients
Inhaled sedation could potentially improve long-term outcomes for paediatric patients.

October 11, 2023
Human-specific protein drives dynamic DNA changes in neurodegenerative conditions
SickKids researchers identified a protein which may be responsible for the progression of genetic conditions and present a new therapeutic target.

October 4, 2023
Hospitalizations for eating disorders increased during pandemic
Emergency department visits and hospital admissions increased among adolescents and young adults during the COVID-19 pandemic.
October 4, 2023
Specialized facility illuminates genetic mechanisms underlying human health conditions
Modelling health conditions in zebrafish is paving the way for genetic discoveries that may change the course of care for children around the world.

September 29, 2023
Celebrating the Patient Support Centre, a critical first step in our campus redevelopment journey
The Patient Support Centre (PSC) ribbon-cutting ceremony celebrates the end of end of major construction activities on the building. This is the latest milestone in our campus redevelopment journey.

September 25, 2023
BORN Ontario cybersecurity incident
BORN Ontario was the victim of a cybersecurity incident earlier this year. Learn more about how this incident may impact you.

September 22, 2023
Update on retroactive lump sum payment for former staff
SickKids will include eligible staff who have left the organization in retro lump sum payments. Eligible former staff will receive an email to their last known personal email address and a letter to their mailing address on file.

September 21, 2023
SickKids celebrates the launch of Precision Child Health, a new era of paediatric care
Precision Child Health pushes past the limits of one-size-fits-all medicine to focus on individualized care.

September 21, 2023
SickKids scientists awarded new funding to advance novel brain research
The Brain Canada funding will support two scientists as they examine preterm brain injury and memory formation in memory-linked brain conditions.
